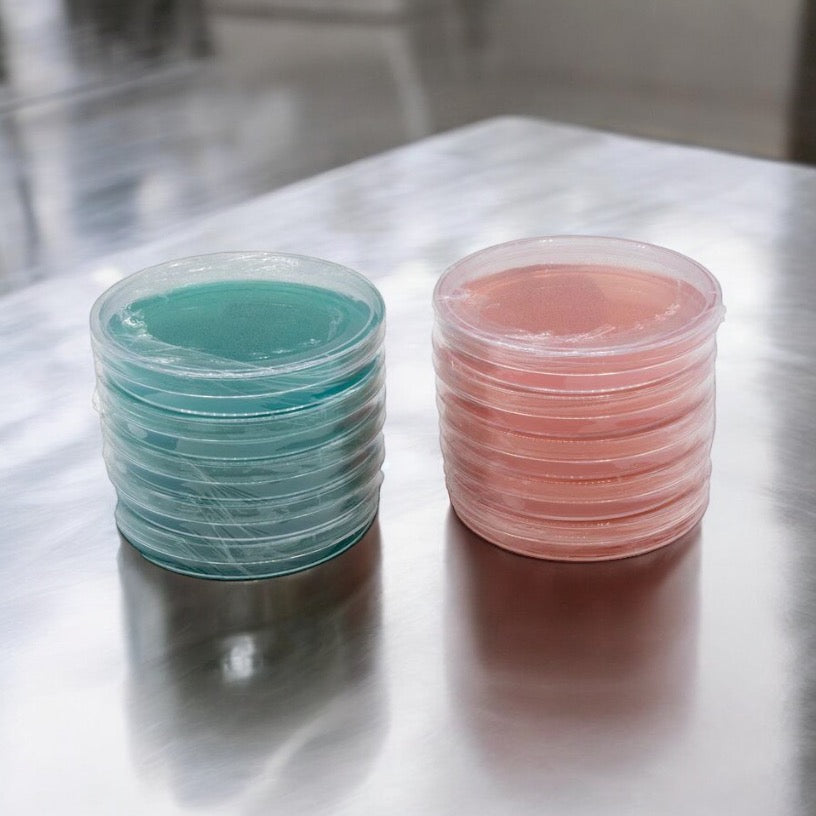

Premium Sterilized Malt Extract Agar Plates - 10 Pack
Microppose Premium Sterilized Light Malt Extract Agar Plates are expertly designed to promote vigorous mycelium growth, making them the top choice for mushroom cultivators. Here’s why they stand out:
- Precision-Formulated for Growth: Each plate contains a meticulously crafted blend of ingredients, optimized to provide ideal conditions for mushroom cultivation.
- Durable Construction: Made with 90mm polystyrene Petri dishes, ensuring both reliability and durability.
- Lab-Grade Sterilization: Each plate undergoes pressure sterilization and is poured in a controlled clean-room environment, maintaining the highest level of purity.
- Color-Coded for Convenience: Plates come in assorted colors, making it easier to track usage dates and optimize results.
- Freshly Prepared: Made fresh daily and sealed in polyfilm for optimal quality.
Ingredients: Agar, Malt Extract, Yeast Extract, and Locust Gum.
Storage and Usage: For best results, store the plates in the refrigerator and use them within 4 weeks of receipt.
What Are Agar Plates Used For?
Agar plates are essential in both microbiology and mycology as a primary medium for growing and isolating microorganisms, including fungi. Made from seaweed-derived agar mixed with nutrients, these plates provide an optimal surface for cultivating mycelium, the vegetative growth of fungi.
In mushroom cultivation, Malt Extract Agar (MEA) is commonly used due to its nutrient-rich composition, which encourages healthy and robust mycelium development. Cultivators use agar plates in the early stages of mushroom growing to propagate and isolate fungal spores or tissue samples. In a sterile environment, spores or tissue are placed on the agar surface, and the plates are incubated at controlled temperatures to allow mycelium growth.
By using agar plates, growers can monitor the health and purity of the mycelium, ensuring it is free of contaminants. Once the mycelium establishes on the plate, it is transferred to other growing mediums like grain or sawdust through a process known as spawning. This step lays the foundation for the development of fruiting bodies—the mushrooms themselves.
Agar plates play a critical role in ensuring a strong, contaminant-free culture that is essential for successful mushroom cultivation.
Premium Sterilized Malt Extract Agar Plates - 10 Pack